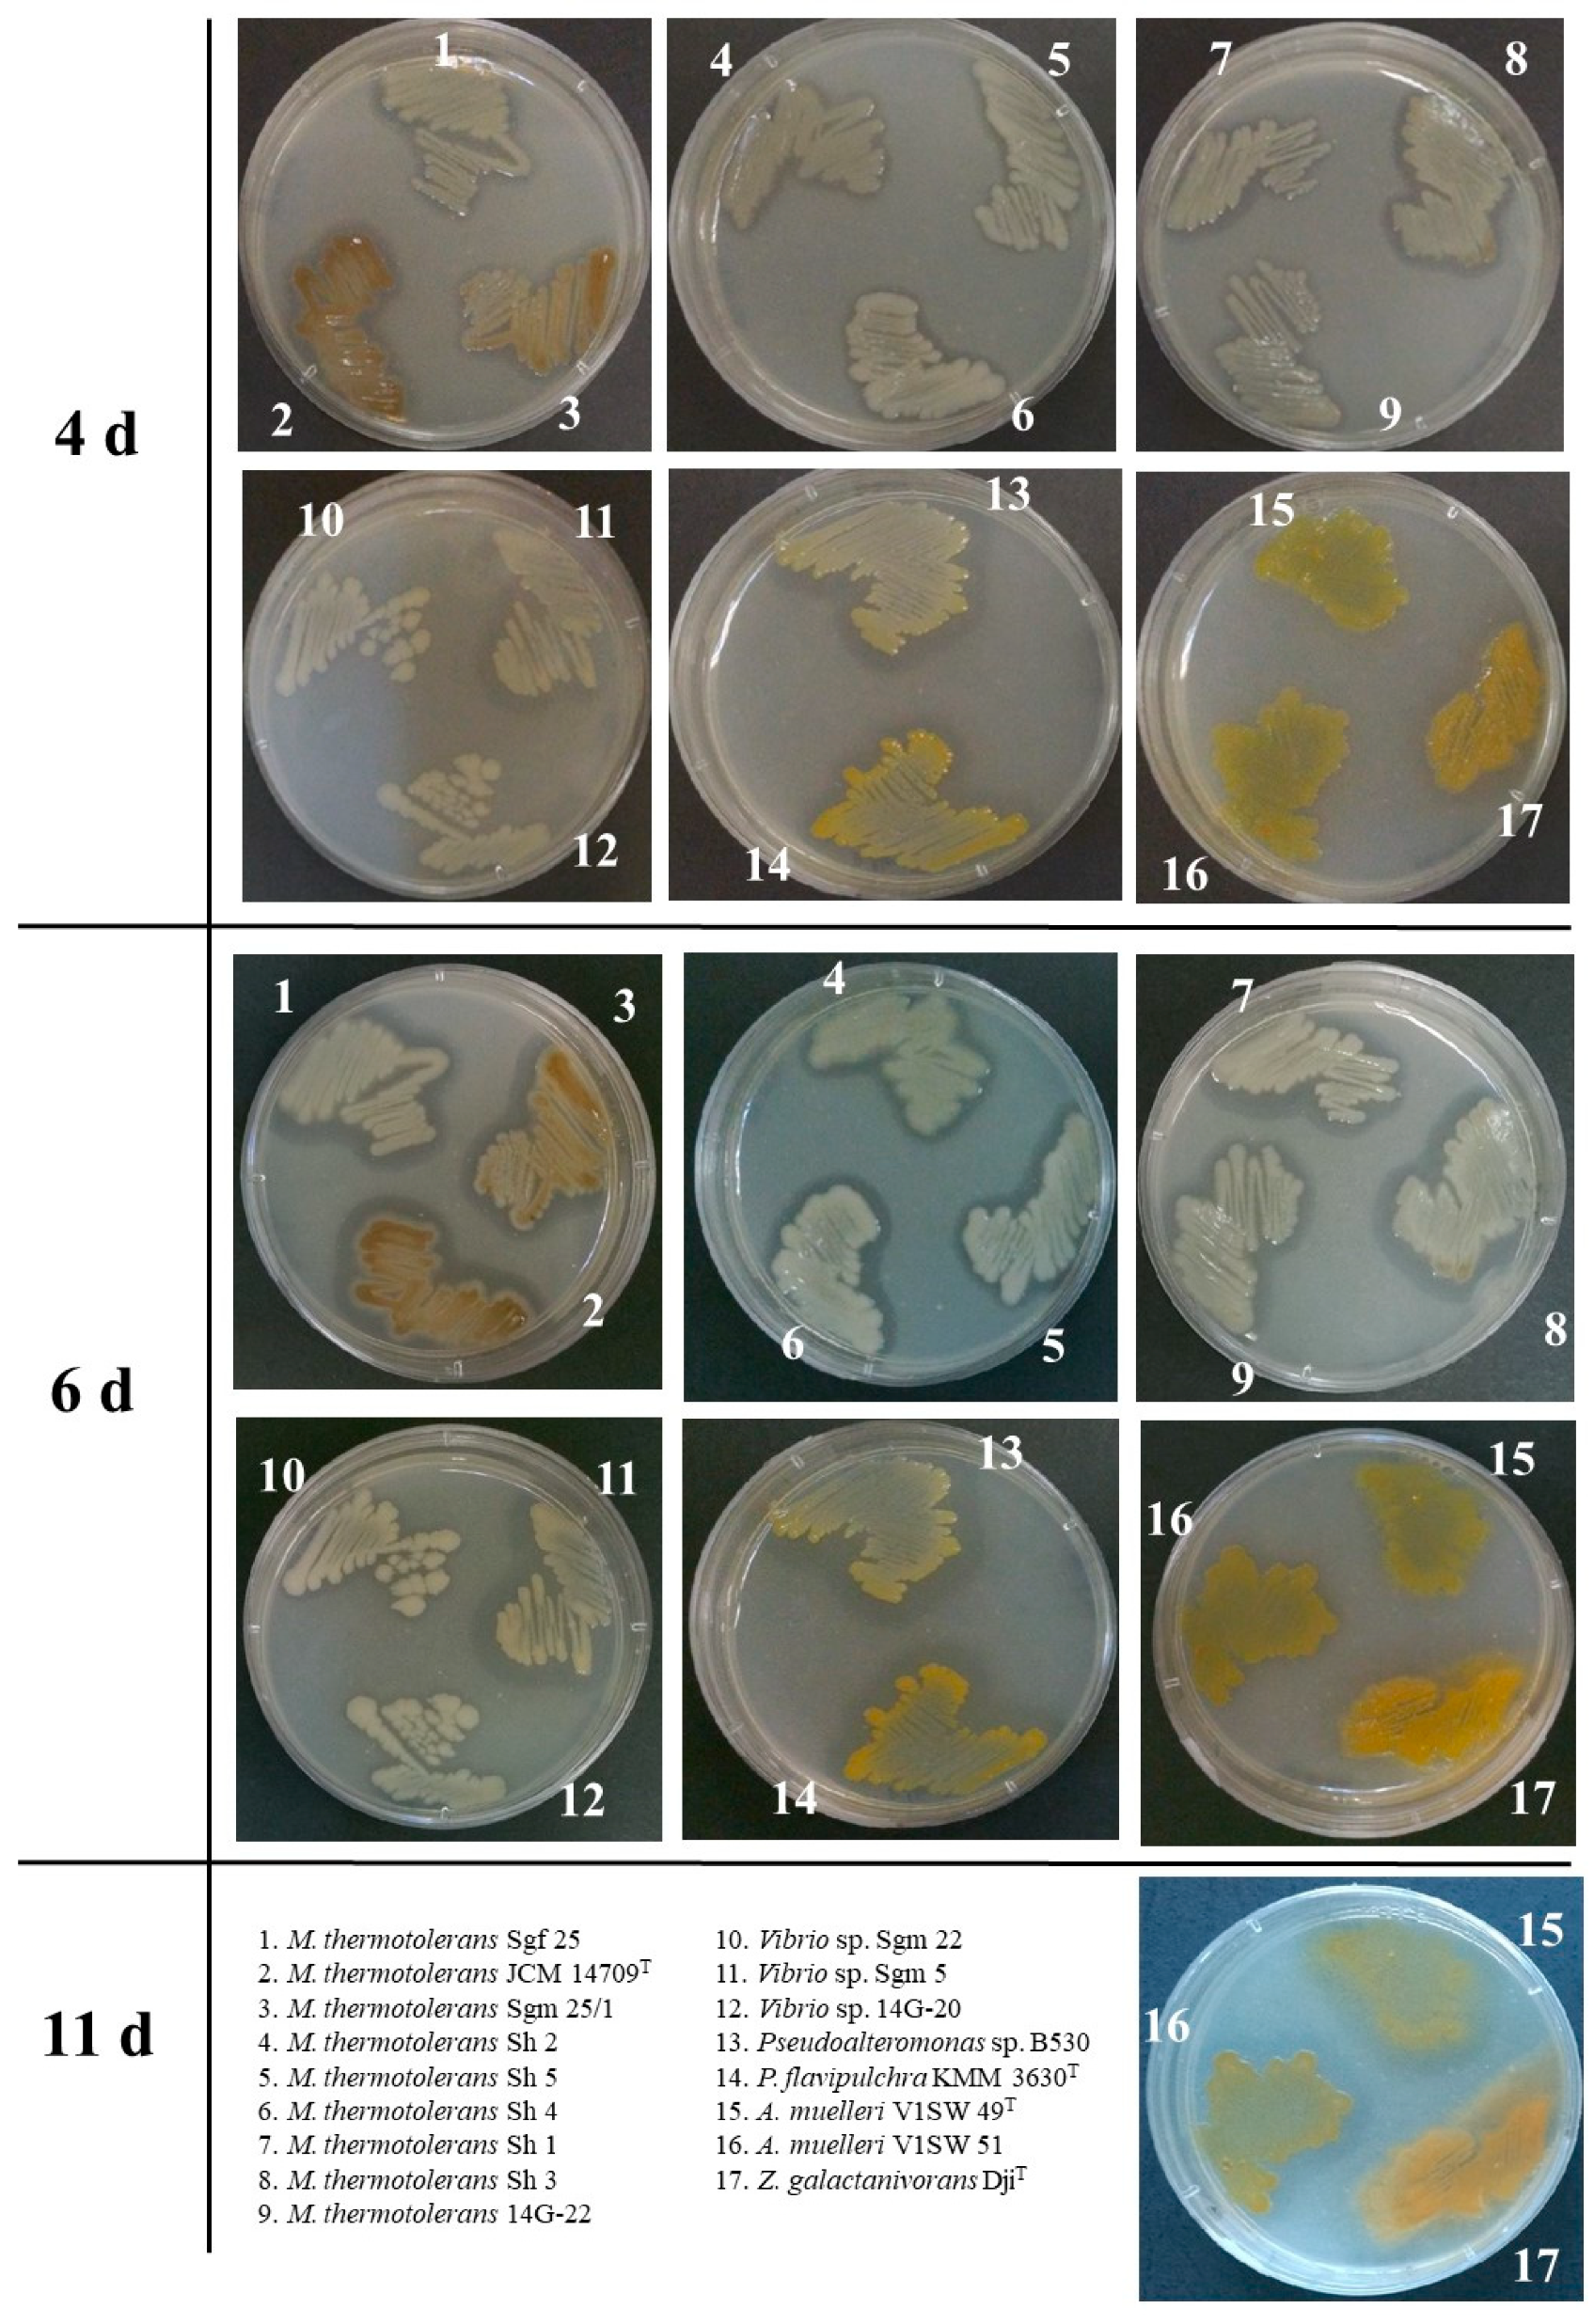
Microorganisms 11 02255 g001 Microorganisms 11 02255 g001
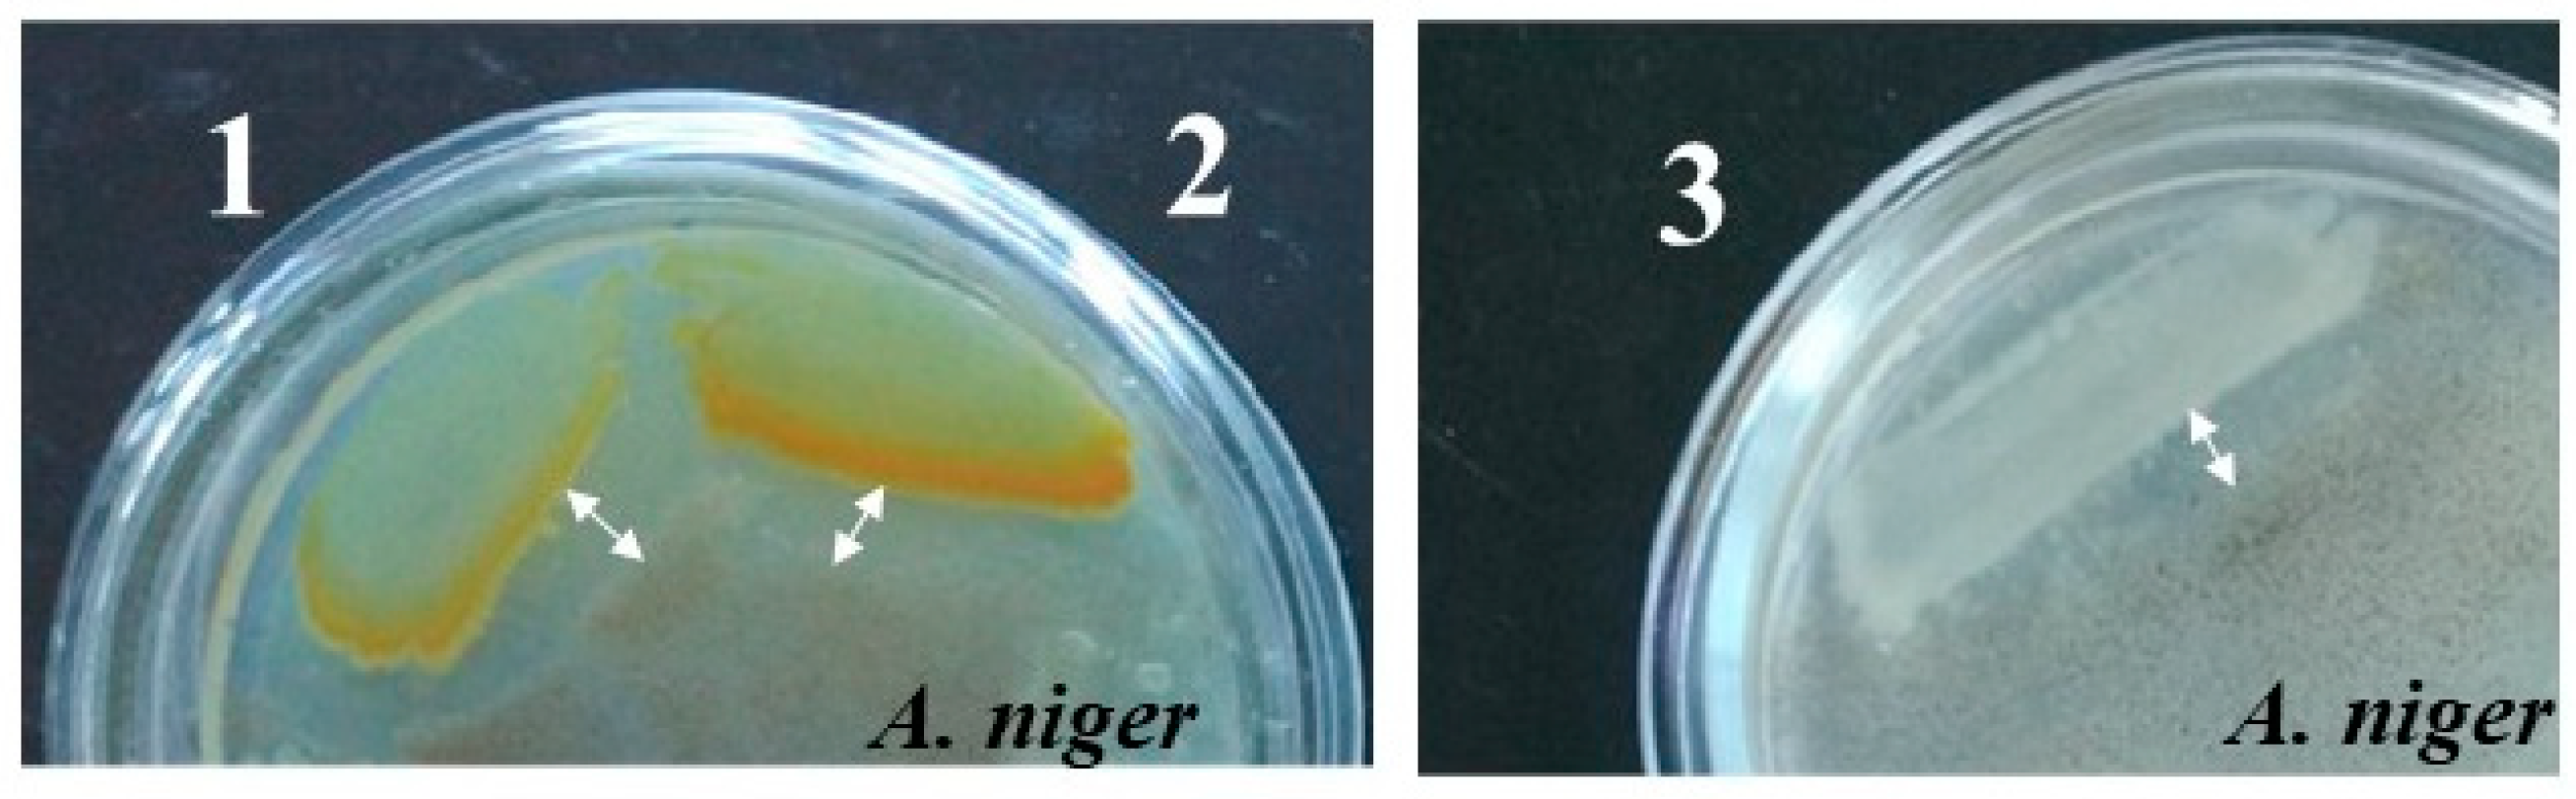
Microorganisms 11 02255 g005 Microorganisms 11 02255 g005

Chitinolytic and Fungicidal Potential of the Marine Bacterial Strains Habituating Pacific Ocean Regions
Abstract
1. Introduction
2. Materials and Methods
2.1. Bacterial Strains and Culture Conditions
2.2. Chemicals
2.3. PCR Amplification and 16S rRNA Gene Sequencing
2.4. Sequencing and Annotation of Genomic DNA
2.5. Whole-Genome-Based Analysis of the Marine Chitinolytic Bacterial Strains
2.6. Chitinase Activity and SDS–PAGE Assay
2.7. Confirmation of Chitinase Gene Functional Annotations
2.8. Antifungal Activity Assay
3. Results and Discission
3.1. Characterization of the Marine Chitinolytic Bacterial Strains
3.2. Whole-Genome-Based Identification of the Marine Chitinolytic Strains
3.3. Chitin-Degrading Activity of the Marine Chitinolytic Strains and the Related Gene Annotations
| № | KMM * | Chitinolytic Activity on Agar Plates | Fungicidal Activity on Agar Plates | Phylum | Strain | Isolation Source | 16S rRNA Gene Accession Numbers | Genome Accession Numbers | Genome Size, kbp | GC, % | CAZyme Family | Chitinase Gene Accession Number | Reference |
|---|---|---|---|---|---|---|---|---|---|---|---|---|---|
| 1. | – | +++ | − | Proteobacteria | Microbulbifer thermotolerans JCM 14709T | A deep-sea sediment in Suruga Bay and Sagami Bay and off Kagoshima, Japan. | AB124836 | CP014864 | 3938 | 56.5 | GH18 (3) | SFC67996 | [45] |
| SFC69774 | |||||||||||||
| SFC69838 | |||||||||||||
| AA10 (1) | SFC52191 | ||||||||||||
| 2. | 6262 | +++ | − | Proteobacteria | Microbulbifer thermotolerans Sgf 25 | At a depth of 3 m in Troitsa Bay, Gulf of Peter the Great, Sea of Japan, Pacific Ocean. Host—sea urchin Strongylocentrotus intermedius | OL744412 | JAPHQH000000000 | 3366 | 56.6 | GH18 (4) | MCX2830300 | this study |
| MCX2831405 | |||||||||||||
| MCX2831407 | |||||||||||||
| MCX2831458 | |||||||||||||
| AA10 (2) | MCX2831189 | ||||||||||||
| MCX2832217 | |||||||||||||
| 3. | 6834 | ++ | − | Proteobacteria | Microbulbifer thermotolerans Sgm 25/1 | At a depth of 3 m in Troitsa Bay, Gulf of Peter the Great, Sea of Japan, Pacific Ocean. Host—sea urchin Strongylocentrotus intermedius | OL744415 | JAPHQG000000000 | 3374 | 56.5 | GH18 (4) | MCX2804080 | this study |
| MCX2804660 | |||||||||||||
| MCX2804711 | |||||||||||||
| MCX2804713 | |||||||||||||
| AA10 (3) | MCX2805714 | ||||||||||||
| MCX2806217 | |||||||||||||
| MCX2806218 | |||||||||||||
| 4. | 6242 | +++ | − | Proteobacteria | Microbulbifer thermotolerans Sh 1 | At a depth of 3 m in Troitsa Bay, Gulf of Peter the Great, Sea of Japan, Pacific Ocean. Host—sea urchin Strongylocentrotus intermedius | OL744416 | JAPHQF000000000 | 3366 | 56.5 | GH18 (4) | MCX2841098 | this study |
| MCX2842232 | |||||||||||||
| MCX2842283 | |||||||||||||
| MCX2842285 | |||||||||||||
| AA10 (2) | MCX2840086 | ||||||||||||
| MCX2842358 | |||||||||||||
| 5. | 6835 | ++ | − | Proteobacteria | Microbulbifer thermotolerans Sh 2 | At a depth of 3 m in Troitsa Bay, Gulf of Peter the Great, Sea of Japan, Pacific Ocean. Host—sea urchin Strongylocentrotus intermedius | OL744417 | JAPHQE000000000 | 3386 | 56.4 | GH18 (4) | MCX2834787 | this study |
| MCX2835292 | |||||||||||||
| MCX2835294 | |||||||||||||
| MCX2835346 | |||||||||||||
| AA10 (2) | MCX2833669 | ||||||||||||
| MCX2835470 | |||||||||||||
| 6. | 6836 | +++ | − | Proteobacteria | Microbulbifer thermotolerans Sh 3 | At a depth of 3 m in Troitsa Bay, Gulf of Peter the Great, Sea of Japan, Pacific Ocean. Host—sea urchin Strongylocentrotus intermedius | OL744418 | JAPHQD000000000 | 3337 | 56.6 | GH18 (4) | MCX2793661 | this study |
| MCX2795686 | |||||||||||||
| MCX2795737 | |||||||||||||
| MCX2795739 | |||||||||||||
| AA10 (2) | MCX2794997 | ||||||||||||
| MCX2795421 | |||||||||||||
| 7. | 6837 | +++ | − | Proteobacteria | Microbulbifer thermotolerans Sh 4 | At a depth of 3 m in Troitsa Bay, Gulf of Peter the Great, Sea of Japan, Pacific Ocean. Host—sea urchin Strongylocentrotus intermedius | OL744419 | JAPHQC000000000 | 3400 | 56.6 | GH18 (4) | MCX2781498 | this study |
| MCX2781500 | |||||||||||||
| MCX2781953 | |||||||||||||
| MCX2784221 | |||||||||||||
| AA10 (2) | MCX2782412 | ||||||||||||
| MCX2783047 | |||||||||||||
| 8. | 6838 | ++ | − | Proteobacteria | Microbulbifer thermotolerans Sh 5 | At a depth of 3 m in Troitsa Bay, Gulf of Peter the Great, Sea of Japan, Pacific Ocean. Host—sea urchin Strongylocentrotus intermedius | OL744420 | JAPHQB000000000 | 3382 | 56.6 | GH18 (4) | MCX2800845 | this study |
| MCX2802019 | |||||||||||||
| MCX2802021 | |||||||||||||
| MCX2802072 | |||||||||||||
| AA10 (2) | MCX2800565 | ||||||||||||
| MCX2802723 | |||||||||||||
| 9. | 6840 | ++ | − | Proteobacteria | Microbulbifer thermotolerans 14G-22 | A marine sediment sample, at a depth of 3 m in Troitsa Bay, Gulf of Peter the Great, Sea of Japan, Pacific Ocean. Host—sea urchin Strongylocentrotus intermedius | OL744423 | JAPHQA000000000 | 3375 | 56.5 | GH18 (4) | MCX2778775 | this study |
| MCX2778989 | |||||||||||||
| MCX2778991 | |||||||||||||
| MCX2779042 | |||||||||||||
| AA10 (3) | MCX2778112 | ||||||||||||
| MCX2778113 | |||||||||||||
| MCX2779384 | |||||||||||||
| 10. | 6832 | +++ | +++ | Proteobacteria | Vibrio sp. Sgm 5 | At a depth of 3 m in Troitsa Bay, Gulf of Peter the Great, Sea of Japan, Pacific Ocean. Host—sea urchin Strongylocentrotus intermedius | OL744413 | JAPHPY000000000 | 5315 | 45.0 | GH18 (2) | MCX2790314 | this study |
| MCX2792044 | |||||||||||||
| GH19 (1) | MCX2791380 | ||||||||||||
| AA10 (2) | MCX2792547 | ||||||||||||
| MCX2792848 | |||||||||||||
| 11. | 6833 | ++ | − | Proteobacteria | Vibrio sp. Sgm 22 | At a depth of 3 m in Troitsa Bay, Gulf of Peter the Great, Sea of Japan, Pacific Ocean. Host—sea urchin Strongylocentrotus intermedius | OL744414 | JAPHPX000000000 | 4528 | 44.4 | GH18 (2) | MCX2775709 | this study |
| MCX2777646 | |||||||||||||
| GH19 (1) | MCX2774415 | ||||||||||||
| AA10 (1) | MCX2774911 | ||||||||||||
| 12. | 6839 | ++ | − | Proteobacteria | Vibrio sp. 14G-20 | A marine sediment sample, at a depth of 3 m in Troitsa Bay, Gulf of Peter the Great, Sea of Japan, Pacific Ocean. Host—sea urchin Strongylocentrotus intermedius | OL744424 | JAPHPW000000000 | 4504 | 44.3 | GH18 (2) | MCX2758330 | this study |
| MCX2760626 | |||||||||||||
| GH19 (1) | MCX2758955 | ||||||||||||
| AA10 (1) | MCX2757810 | ||||||||||||
| 13. | 6020T | + | − | Bacteroidetes | Aquimarina muelleri V1SW 49T | A sea water sample collected in Amursky Bay, Gulf of Peter the Great, Sea of Japan | AY608406 | BMWS00000000 | 4958 | 31.0 | GH18 (2) | WP_027414378 | [48] |
| WP_081414620 | |||||||||||||
| LPMO (1) | WP_051316619 | ||||||||||||
| 14. | 6556 | + | − | Bacteroidetes | Aquimarina muelleri V1SW 51 | A sea water sample, Amursky Bay, Gulf of Peter the Great, Sea of Japan, Russia | OL744421 | JAPHPZ000000000 | 4152 | 31.4 | GH18 (2) | MCX2762229 | this study |
| MCX2764142 | |||||||||||||
| AA10 (1) | MCX2761469 | ||||||||||||
| 15. | 3630T | ++ | +++ | Proteobacteria | Pseudoalteromonas flavipulchra NCMB 2033 | A sea water sample collected in the Mediterranean Sea, Nice, France | AF297958 | AQGY00000000 | 5441 | 43.0 | GH18 (3) | MBE0371971 | [47] |
| MBE0375554 | |||||||||||||
| MBE0375556 | |||||||||||||
| LPMO (2) | MBE0375052 | ||||||||||||
| MBE0375555 | |||||||||||||
| 16. | 6841 | +++ | +++ | Proteobacteria | Pseudoalteromonas sp. B530 | A sea water sample, a mussel farm located in a lagoon of Nha Trang Bay, South China Sea, Viet Nam | OL744422 | JAPHPV000000000 | 4720 | 43.1 | GH18 (3) | MCX2765851 | this study |
| MCX2765853 | |||||||||||||
| MCX2769256 | |||||||||||||
| GH19 (1) | MCX2767687 | ||||||||||||
| AA10 (2) | MCX2765852 | ||||||||||||
| MCX2767081 | |||||||||||||
| 17. | – | + | − | Bacteroidetes | Zobellia galactanivorans DjiT | A red seaweed in Roscoff (Brittany, France) | FP476056 | FP476056 | 5522 | 42.5 | GH18 (2) | CAZ95072 | [58] |
| CAZ97205 | |||||||||||||
| GH23 | CAZ95778 | ||||||||||||
| CAZ94149 |
3.4. Chitin-Degrading Activity of the Recombinant Proteins Derived from the Predicted Genes of the Marine Chitinolytic Strains
3.5. Antifungal Activity of the Marine Chitinolytic Strains
4. Conclusions
Supplementary Materials
Author Contributions
Funding
Data Availability Statement
Conflicts of Interest
References
- Debashish, G.; Malay, S.; Barindra, S.; Joydeep, M. Marine enzymes. Adv. Biochem. Eng. Biotechnol. 2005, 96, 189–218. [Google Scholar] [CrossRef] [PubMed]
- Blumenthal, H.J.; Roseman, S. Quantitative estimation of chitin in fungi. J. Bacteriol. 1957, 74, 222–224. [Google Scholar] [CrossRef] [PubMed]
- Younes, I.; Rinaudo, M. Chitin and chitosan preparation from marine sources. Structure, properties and applications. Mar. Drugs 2015, 13, 1133–1174. [Google Scholar] [CrossRef]
- Jiang, W.X.; Li, P.Y.; Chen, X.L.; Zhang, Y.-S.; Wang, J.-P.; Wang, Y.-J.; Sheng, Q.; Sun, Z.-Z.; Qin, Q.-L.; Ren, X.-B.; et al. A pathway for chitin oxidation in marine bacteria. Nat. Commun. 2022, 13, 5899. [Google Scholar] [CrossRef]
- Orlando, M.; Buchholz, P.C.F.; Lotti, M.; Pleiss, J. The GH19 Engineering Database: Sequence diversity, substrate scope, and evolution in glycoside hydrolase family 19. PLoS ONE 2021, 16, e0256817. [Google Scholar] [CrossRef] [PubMed]
- Henrissat, B. A classification of glycosyl hydrolases based on amino acid sequence similarities. Biochem. J. 1991, 280, 309–316. [Google Scholar] [CrossRef]
- Brameld, K.A.; Shrader, W.D.; Imperiali, B.; Goddard, W.A., III. Substrate assistance in the mechanism of family 18 chitinases: Theoretical studies of potential intermediates and inhibitors. J. Mol. Biol. 1998, 280, 913–923. [Google Scholar] [CrossRef]
- Brameld, K.A.; Goddard, W.A., III. The role of enzyme distortion in the single displacement mechanism of family 19 chitinases. Proc. Natl. Acad. Sci. USA 1998, 95, 4276–4281. [Google Scholar] [CrossRef]
- Suzuki, K.; Taiyoji, M.; Sugawara, N.; Nikaidou, N.; Henrissat, B.; Watanabe, T. The third chitinase gene (chiC) of Serratia marcescens 2170 and the relationship of its product to other bacterial chitinases. Biochem. J. 1999, 343, 587–596. [Google Scholar] [CrossRef]
- Ohno, T.; Armand, S.; Hata, T.; Nikaidou, N.; Henrissat, B.; Mitsutomi, M.; Watanabe, T. A modular family 19 chitinase found in the prokaryotic organism Streptomyces griseus HUT 6037. J. Bacteriol. 1996, 178, 5065–5070. [Google Scholar] [CrossRef]
- Taira, T.; Mahoe, Y.; Kawamoto, N.; Onaga, S.; Iwasaki, H.; Ohnuma, T.; Fukamizo, T. Cloning and characterization of a small family 19 chitinase from moss (Bryum coronatum). Glycobiology 2011, 21, 644–654. [Google Scholar] [CrossRef] [PubMed]
- Pentekhina, I.; Hattori, T.; Tran, D.M.; Shima, M.; Watanabe, T.; Sugimoto, H.; Suzuki, K. Chitinase system of Aeromonas salmonicida, and characterization of enzymes involved in chitin degradation. Biosci. Biotechnol. Biochem. 2020, 84, 1936–1947. [Google Scholar] [CrossRef]
- Tanaka, J.; Fukamizo, T.; Ohnuma, T. Enzymatic properties of a GH19 chitinase isolated from rice lacking a major loop structure involved in chitin binding. Glycobiology 2017, 27, 477–485. [Google Scholar] [CrossRef] [PubMed]
- Vaaje-Kolstad, G.; Horn, S.J.; Sørlie, M.; Eijsink, V.G.H. The chitinolytic machinery of Serratia marcescens—A model system for enzymatic degradation of recalcitrant polysaccharide. FEBS J. 2013, 280, 3028–3049. [Google Scholar] [CrossRef]
- Suzuki, K.; Sugawara, N.; Suzuki, M.; Uchiyama, T.; Katouno, F.; Nikaidou, N.; Watanabe, T. Chitinases A, B, and C1 of Serratia marcescens 2170 produced by recombinant Escherichia coli: Enzymatic properties and synergism on chitin degradation. Biosci. Biotechnol. Biochem. 2002, 66, 1075–1083. [Google Scholar] [CrossRef] [PubMed]
- Paulsen, S.S.; Andersen, B.; Gram, L.; Machado, H. Biological potential of chitinolytic marine bacteria. Mar. Drugs 2016, 14, 230. [Google Scholar] [CrossRef]
- Zou, Y.; Robbens, J.; Heyndrickx, M.; Debode, J.; Raes, K. Quantification of extracellular proteases and chitinases from marine bacteria. Curr. Microbiol. 2020, 77, 3927–3936. [Google Scholar] [CrossRef]
- Raimundo, I.; Silva, R.; Meunier, L.; Valente, S.M.; Lago-Lestón, A.; Keller-Costa, T.; Costa, R. Functional metagenomics reveals differential chitin degradation and utilization features across free-living and host-associated marine microbiomes. Microbiome 2021, 9, 43. [Google Scholar] [CrossRef]
- Wong, E.; Vaaje-Kolstad, G.; Ghosh, A.; Hurtado-Guerrero, R.; Konarev, P.V.; Ibrahim, A.F.M.; Svergun, D.I.; Eijsink, V.G.H.; Chatterjee, N.S.; van Aalten, D.M.F. The Vibrio cholerae colonization factor GbpA possesses a modular structure that governs binding to different host surfaces. PLoS Pathog. 2012, 8, e1002373. [Google Scholar] [CrossRef]
- Skåne, A.; Minniti, G.; Loose, J.S.M.; Mekasha, S.; Bissaro, B.; Mathiesen, G.; Arntzen, M.Ø.; Vaaje-Kolstad, G. The fish pathogen Aliivibrio salmonicida LFI1238 can degrade and metabolize chitin despite gene disruption in the chitinolytic pathway. Appl. Environ. Microbiol. 2021, 87, e00529-21. [Google Scholar] [CrossRef]
- Lee, H.-J.; Lee, Y.-S.; Choi, Y.-L. Cloning, purification, and characterization of an organic solvent-tolerant chitinase, MtCh509, from Microbulbifer thermotolerans DAU221. Biotechnol. Biofuels 2018, 11, 303. [Google Scholar] [CrossRef] [PubMed]
- Wang, X.; Chi, N.; Bai, F.; Du, Y.; Zhao, Y.; Yin, H. Characterization of a cold-adapted and salt-tolerant exo-chitinase (ChiC) from Pseudoalteromonas sp. DL-6. Extremophiles 2016, 20, 167–176. [Google Scholar] [CrossRef] [PubMed]
- Ren, X.-B.; Dang, Y.-R.; Liu, S.-S.; Huang, K.-X.; Qin, Q.-L.; Chen, X.-L.; Zhang, Y.-Z.; Wang, Y.-J.; Li, P.-Y. Identification and characterization of three chitinases with potential in direct conversion of crystalline chitin into N,N’-diacetylchitobiose. Mar. Drugs 2022, 20, 165. [Google Scholar] [CrossRef] [PubMed]
- Berger, L.R.; Reynolds, D.M. The chitinase system of a strain of Streptomyces griseus. Biochim. Biophys. Acta 1958, 29, 522–534. [Google Scholar] [CrossRef]
- Noskova, Y.; Seitkalieva, A.; Nedashkovskaya, O.; Shevchenko, L.; Tekutyeva, L.; Son, O.; Balabanova, L. Are the closely related Cobetia strains of different species? Molecules 2021, 26, 690. [Google Scholar] [CrossRef]
- Bolger, A.M.; Lohse, M.; Usadel, B. Trimmomatic: A flexible trimmer for Illumina sequence data. Bioinformatics 2014, 30, 2114–2120. [Google Scholar] [CrossRef]
- Bankevich, A.; Nurk, S.; Antipov, D.; Gurevich, A.A.; Dvorkin, M.; Kulikov, A.S.; Lesin, V.M.; Nikolenko, S.I.; Pham, S.; Prjibelski, A.D.; et al. SPAdes: A new genome assembly algorithm and its applications to single-cell sequencing. J. Comput. Biol. 2012, 19, 455–477. [Google Scholar] [CrossRef]
- Tatusova, T.; DiCuccio, M.; Badretdin, A.; Chetvernin, V.; Nawrocki, E.P.; Zaslavsky, L.; Lomsadze, A.; Pruitt, K.D.; Borodovsky, M.; Ostell, J. NCBI prokaryotic genome annotation pipeline. Nucleic Acids Res. 2016, 44, 6614–6624. [Google Scholar] [CrossRef]
- Meier-Kolthoff, J.P.; Göker, M. TYGS is an automated high-throughput platform for state-of-the-art genome-based taxonomy. Nat. Commun. 2019, 10, 2182. [Google Scholar] [CrossRef]
- Ondov, B.D.; Treangen, T.J.; Melsted, P.; Mallonee, A.B.; Bergman, N.H.; Koren, S.; Phillippy, A.M. Mash: Fast genome and metagenome distance estimation using MinHash. Genome Biol. 2016, 17, 132. [Google Scholar] [CrossRef]
- Lagesen, K.; Hallin, P.; Rødland, E.A.; Stærfeldt, H.-H.; Rognes, T.; Ussery, D.W. RNAmmer: Consistent and rapid annotation of ribosomal RNA genes. Nucleic Acids Res. 2007, 35, 3100–3108. [Google Scholar] [CrossRef] [PubMed]
- Camacho, C.; Coulouris, G.; Avagyan, V.; Ma, N.; Papadopoulos, J.; Bealer, K.; Madden, T.L. BLAST+: Architecture and applications. BMC Bioinform. 2009, 10, 421. [Google Scholar] [CrossRef] [PubMed]
- Meier-Kolthoff, J.P.; Auch, A.F.; Klenk, H.-P.; Göker, M. Genome sequence-based species delimitation with confidence intervals and improved distance functions. BMC Bioinform. 2013, 14, 60. Available online: http://www.biomedcentral.com/1471-2105/14/60 (accessed on 15 December 2022). [CrossRef] [PubMed]
- Lefort, V.; Desper, R.; Gascuel, O. FastME 2.0: A Comprehensive, Accurate, and Fast Distance-Based Phylogeny Inference Program. Mol. Biol. Evol. 2015, 32, 2798–2800. [Google Scholar] [CrossRef]
- Kreft, L.; Botzki, A.; Coppens, F.; Vandepoele, K.; Bel, M.V. PhyD3: A phylogenetic tree viewer with extended phyloXML support for functional genomics data visualization. Bioinformatics 2017, 33, 2946–2947. [Google Scholar] [CrossRef]
- Meier-Kolthoff, J.P.; Hahnke, R.L.; Petersen, J.; Scheuner, C.; Michael, V.; Fiebig, A.; Rohde, C.; Rohde, M.; Fartmann, B.; Goodwin, L.A.; et al. Complete genome sequence of DSM 30083(T), the type strain (U5/41(T)) of Escherichia coli, and a proposal for delineating subspecies in microbial taxonomy. Stand. Genom. Sci. 2014, 9, 2. [Google Scholar] [CrossRef]
- Yoon, S.-H.; Ha, S.-M.; Lim, J.; Kwon, S.; Chun, J. A large-scale evaluation of algorithms to calculate average nucleotide identity. Antonie Leeuwenhoek 2017, 110, 1281–1286. [Google Scholar] [CrossRef]
- Bradford, M.M. A rapid and sensitive method for quantitation of microgram quantities of protein utilizing the principle of protein-dye binding. Anal. Biochem. 1976, 72, 248–254. [Google Scholar] [CrossRef]
- Laemmli, U.K. Cleavage of structural proteins during the assembly of the head of bacteriophage T4. Nature 1970, 227, 680–685. [Google Scholar] [CrossRef]
- Imoto, T.; Yagishita, K. A simple activity measurement of lysozyme. Agric. Biol. Chem. 1971, 35, 1154–1156. [Google Scholar] [CrossRef]
- Paulsen, S.S.; Strube, M.L.; Bech, P.K.; Gram, L.; Sonnenschein, E.C. Marine chitinolytic Pseudoalteromonas represents an untapped reservoir of bioactive potential. Appl. Environ. Sci. 2019, 4, e00060-19. [Google Scholar] [CrossRef] [PubMed]
- Yoon, S.H.; Ha, S.M.; Kwon, S.; Lim, J.; Kim, Y.; Seo, H.; Chun, J. Introducing EzBioCloud: A taxonomically united database of 16S rRNA gene sequences and whole-genome assemblies. Int. J. Syst. Evol. Microbiol. 2017, 67, 1613–1617. [Google Scholar] [CrossRef] [PubMed]
- Balabanova, L.; Nedashkovskaya, O.; Otstavnykh, N.; Isaeva, M.; Kolpakova, O.; Pentehina, I.; Seitkalieva, A.; Noskova, Y.; Stepochkina, V.; Son, O.; et al. Computational Insight into Intraspecies Distinctions in Pseudoalteromonas distincta: Carotenoid-like Synthesis Traits and Genomic Heterogeneity. Int. J. Mol. Sci. 2023, 24, 4158. [Google Scholar] [CrossRef] [PubMed]
- Yu, J.; Zhu, B.; Zhou, T.; Wei, Y.; Li, X.; Liu, Y. Species-specific Identification of Vibrio sp. based on 16S-23S rRNA gene internal transcribed spacer. J. Appl. Microbiol. 2020, 129, 738–752. [Google Scholar] [CrossRef]
- Miyazaki, M.; Nogi, Y.; Ohta, Y.; Hatada, Y.; Fujiwara, Y.; Ito, S.; Horikoshi, K. Microbulbifer agarilyticus sp. nov. and Microbulbifer thermotolerans sp. nov., agar-degrading bacteria isolated from deep-sea sediment. Int. J. Syst. Evol. Microbiol. 2008, 58, 1128–1133. [Google Scholar] [CrossRef]
- Belous, O.S.; Drozdov, A.L. Trinity Bay (Peter the Great Bay, Sea of Japan): Physical-geographic characteristics and macrobenthos. Biodivers. Environ. Far East Reserves 2015, 1, 3–12. [Google Scholar]
- Ivanova, E.P.; Shevchenko, L.S.; Sawabe, T.; Lysenko, A.M.; Svetashev, V.I.; Gorshkova, N.M.; Satomi, M.; Christen, R.; Mikhailov, V.V. Pseudoalteromonas maricaloris sp. nov., isolated from an Australian sponge, and reclassification of [Pseudoalteromonas aurantia] NCIMB 2033 as Pseudoalteromonas flavipulchra sp. nov. Int. J. Syst. Evol. Microbiol. 2002, 52, 263–271. [Google Scholar] [CrossRef]
- Nedashkovskaya, O.I.; Kim, S.B.; Lysenko, A.M.; Frolova, G.M.; Mikhailov, V.V.; Lee, K.H.; Bae, K.S. Description of Aquimarina muelleri gen. nov., sp. nov., and proposal of the reclassification of [Cytophaga] latercula Lewin 1969 as Stanierella latercula gen. nov., comb. nov. Int. J. Syst. Evol. Microbiol. 2005, 55, 225–229. [Google Scholar] [CrossRef][Green Version]
- Dudek, M.; Dieudonné, A.; Jouanneau, D.; Rochat, T.; Michel, G.; Sarels, B.; Thomas, F. Regulation of alginate catabolism involves a GntR family repressor in the marine flavobacterium Zobellia galactanivorans DsijT. Nucleic Acids Res. 2020, 48, 7786–7800. [Google Scholar] [CrossRef]
- Ito, M.; Watanabe, K.; Maruyama, T.; Mori, T.; Niwa, K.; Chow, S.; Takeyama, H. Enrichment of bacteria and alginate lyase genes potentially involved in brown alga degradation in the gut of marine gastropods. Sci. Rep. 2019, 9, 2129. [Google Scholar] [CrossRef]
- Vázquez-Rosas-Landa, M.; Ponce-Soto, G.Y.; Aguirre-Liguori, J.A.; Thakur, S.; Scheinvar, E.; Barrera-Redondo, J.; Ibarra-Laclette, E.; Guttman, D.S.; Eguiarte, L.E.; Souza, V. Population genomics of Vibrionaceae isolated from an endangered oasis reveals local adaptation after an environmental perturbation. BMC Genom. 2020, 21, 418. [Google Scholar] [CrossRef]
- Urbanczyk, Y.; Ogura, Y.; Hayashi, T.; Urbanczyk, H. Genomic evidence that Vibrio inhibens is a heterotypic synonym of Vibrio jasicida. Int. J. Syst. Evol. Microbiol. 2016, 66, 3214–3218. [Google Scholar] [CrossRef]
- Forsberg, Z.; Nelson, C.E.; Dalhus, B.; Mekasha, S.; Loose, J.S.M.; Crouch, L.I.; Røhr, Å.K.; Gardner, J.G.; Eijsink, V.G.H.; Vaaje-Kolstad, G. Structural and Functional Analysis of a Lytic Polysaccharide Monooxygenase Important for Efficient Utilization of Chitin in Cellvibrio japonicus. J. Biol. Chem. 2016, 291, 7300–7312. [Google Scholar] [CrossRef] [PubMed]
- Hirano, T.; Okubo, M.; Tsuda, H.; Yokoyama, M.; Hakamata, W.; Nishio, T. Chitin Heterodisaccharide, Released from Chitin by Chitinase and Chitin Oligosaccharide Deacetylase, Enhances the Chitin-Metabolizing Ability of Vibrio parahaemolyticus. J. Bacteriol. 2019, 201, e00270-19. [Google Scholar] [CrossRef] [PubMed]
- Wang, X.; Isbrandt, T.; Strube, M.L.; Paulsen, S.S.; Nielsen, M.W.; Buijs, Y.; Schoof, E.M.; Larsen, T.O.; Gram, L.; Zhang, S.-D. Chitin Degradation Machinery and Secondary Metabolite Profiles in the Marine Bacterium Pseudoalteromonas rubra S4059. Mar. Drugs 2021, 19, 108. [Google Scholar] [CrossRef]
- Hehemann, J.-H.; Correc, G.; Thomas, F.; Bernard, T.; Barbeyron, T.; Jam, M.; Helbert, W.; Michel, G.; Czjzek, M. Biochemical and structural characterization of the complex agarolytic enzyme system from the marine bacterium Zobellia galactanivorans. J. Biol. Chem. 2012, 287, 30571–30584. [Google Scholar] [CrossRef] [PubMed]
- Ueda, M.; Ohata, K.; Konishi, T.; Sutrisno, A.; Okada, H.; Nakazawa, M.; Miyatake, K. A novel goose-type lysozyme gene with chitinolytic activity from the moderately thermophilic bacterium Ralstonia sp. A-471: Cloning, sequencing, and expression. Appl. Microbiol. Biotechnol. 2009, 81, 1077–1085. [Google Scholar] [CrossRef] [PubMed]
- Barbeyron, T.; Thomas, F.; Barbe, V.; Teeling, H.; Schenowitz, C.; Dossat, C.; Goesmann, A.; Leblanc, C.; Glöckner, F.O.; Czjzek, M.; et al. Habitat and taxon as driving forces of carbohydrate catabolism in marine heterotrophic bacteria: Example of the model algae-associated bacterium Zobellia galactanivorans DsijT. Environ. Microbiol. 2016, 18, 4610–4627. [Google Scholar] [CrossRef]
- Golotin, V.; Balabanova, L.; Likhatskaya, G.; Rasskazov, V. Recombinant production and characterization of a highly active alkaline phosphatase from marine bacterium Cobetia marina. Mar. Biotechnol. 2015, 17, 130–143. [Google Scholar] [CrossRef]
- Nishitani, Y.; Horiuchi, A.; Aslam, M.; Kanai, T.; Atomi, H.; Miki, K. Crystal structures of an archaeal chitinase ChiD and its ligand complexes. Glycobiology 2018, 28, 418–426. [Google Scholar] [CrossRef]
- Poria, V.; Rana, A.; Kumari, A.; Grewal, J.; Pranaw, K.; Singh, S. Current Perspectives on Chitinolytic Enzymes and Their Agro-Industrial Applications. Biology 2021, 10, 1319. [Google Scholar] [CrossRef] [PubMed]
- Tran, T.N.; Doan, C.T.; Nguyen, M.T.; Nguyen, V.B.; Vo, T.P.K.; Nguyen, A.D.; Wang, S.L. An Exochitinase with N-Acetyl-β-Glucosaminidase-Like Activity from Shrimp Head Conversion by Streptomyces speibonae and Its Application in Hydrolyzing β-Chitin Powder to Produce N-Acetyl-d-Glucosamine. Polymers 2019, 11, 1600. [Google Scholar] [CrossRef] [PubMed]
- Watanabe, T.; Kanai, R.; Kawase, T.; Tanabe, T.; Mitsutomi, M.; Sakuda, S.; Miyashita, K. Family 19 chitinases of Streptomyces species: Characterization and distribution. Microbiology 1999, 145, 3353–3363. [Google Scholar] [CrossRef] [PubMed]
- Tsujibo, H.; Okamoto, T.; Hatano, N.; Miyamoto, K.; Watanabe, T.; Mitsutomi, M.; Inamori, Y. Family 19 chitinases from Streptomyces thermoviolaceus OPC-520: Molecular cloning and characterization. Biosci. Biotechnol. Biochem. 2000, 64, 2445–2453. [Google Scholar] [CrossRef]
- Kawase, T.; Yokokawa, S.; Saito, A.; Fujii, T.; Nikaidou, N.; Miyashita, K.; Watanabe, T. Comparison of enzymatic and antifungal properties between family 18 and 19 chitinases from S. coelicolor A3(2). Biosci. Biotechnol. Biochem. 2006, 70, 988–998. [Google Scholar] [CrossRef]
- Honda, Y.; Taniguchi, H.; Kitaoka, M. A reducing-end-acting chitinase from Vibrio proteolyticus belonging to glycoside hydrolase family 19. Appl. Microbiol. Biotechnol. 2008, 78, 627–634. [Google Scholar] [CrossRef]

| Primers | ID GenBank | Enzyme Activity | |||||
|---|---|---|---|---|---|---|---|
| Gene Name * | Forward (5′-3′) (Restriction **) | Reverse (5′-3′) (Restriction, Annealing ***) | Gene Length, bp | Protein MW; Isoelectric Point | Colloidal Chitin, U/mg | 4-Nitrophenyl N-Acetyl-β-D-glucosaminide, U/mg | |
| Microbulbifer thermotolerans Sgf 25 | |||||||
| GH18 family | |||||||
| 531 Sgf 25 | tatagagctccttcgattgcagtggtttgc (Sac I) | tatactcgagttaaaggttgtcgaggaatgtcc (XhoI, 55 °C) | MCX2830300 | 1596 | 56.67 kDa 4.99 pI | 0.055 ± 0.002 | ND **** |
| 509 Sgf 25 | tatagagctccgtggactgcagaagtctgc (Sac I) | tatagtcgacttagggcagattgtgtacatg (Sal I, 55 °C) | MCX2831405 | 1530 | 52.78 kDa 4.37 pI | 0.048 ± 0.001 | 0.00069 ± 0.00003 |
| 571 Sgf 25 | tataccatggcgtacgattgcggaggcgtac (Nco I) | tatagagctcctactgattactgtgcatggcttc (Sac I, 55 °C) | MCX2831407 | 1716 | 59.91 kDa 4.38 pI | 0.163 ± 0.004 | 0.00023 ± 0.00001 |
| 1036 Sgf 25 | tatagagctcctacgattgcagcgggctg (Sac I) | tatactcgagttaattcgctgagcaaatgagtgtc (XhoI, 62 °C) | MCX2831458 | 3111 | 111.3 kDa 4.28 pI | 0.073 ± 0.002 | ND |
| Zobellia galactanivorans DjiT | |||||||
| GH18 family | |||||||
| 527 DjiT | tataccatggaggaacaaagtttggatcagg (NcoI) | tatagagctcttaattacaagaccgtaccacc (SacI, 72 °C) | CAZ95072.1 | 1584 | 56.63 kDa 4.35 pI | ND | 0.00140 ± 0.00006 |
| 440 DjiT | tataccatggcgagtgatgatactaattattcttcacc (NcoI) | tatagagctcctaattaaactgattaagtatatc (SacI, 45 °C) | CAZ97205.1 | 1323 | 49.41 kDa 4.46 pI | 0.047 ± 0.002 | 0.00113 ± 0.00004 |
| GH23 family | |||||||
| 547 DjiT | tataccatggcgcaagaacaggaaagagattctg (NcoI) | tatactcgagttacgatgaacattcgcac (XhoI, 50 °C) | CAZ95778.1 | 1644 | 62.25 kDa 8.23 pI | 0.030 ± 0.001 | 0.00078 ± 0.00002 |
| 321 DjiT | tataccatggtacaaaataatgtagaaccgag (NcoI) | tatagagctcctacttacctaccctataatac (SacI, 50 °C) | CAZ94149.1 | 966 | 36.73 kDa 5.15 pI | 0.009 ± 0.001 | 0.00080 ± 0.00003 |
Disclaimer/Publisher’s Note: The statements, opinions and data contained in all publications are solely those of the individual author(s) and contributor(s) and not of MDPI and/or the editor(s). MDPI and/or the editor(s) disclaim responsibility for any injury to people or property resulting from any ideas, methods, instructions or products referred to in the content. |
© 2023 by the authors. Licensee MDPI, Basel, Switzerland. This article is an open access article distributed under the terms and conditions of the Creative Commons Attribution (CC BY) license (https://creativecommons.org/licenses/by/4.0/).
Share and Cite
Pentekhina, I.; Nedashkovskaya, O.; Seitkalieva, A.; Gorbach, V.; Slepchenko, L.; Kirichuk, N.; Podvolotskaya, A.; Son, O.; Tekutyeva, L.; Balabanova, L. Chitinolytic and Fungicidal Potential of the Marine Bacterial Strains Habituating Pacific Ocean Regions. Microorganisms 2023, 11, 2255. https://doi.org/10.3390/microorganisms11092255
Pentekhina I, Nedashkovskaya O, Seitkalieva A, Gorbach V, Slepchenko L, Kirichuk N, Podvolotskaya A, Son O, Tekutyeva L, Balabanova L. Chitinolytic and Fungicidal Potential of the Marine Bacterial Strains Habituating Pacific Ocean Regions. Microorganisms. 2023; 11(9):2255. https://doi.org/10.3390/microorganisms11092255
Chicago/Turabian StylePentekhina, Iuliia, Olga Nedashkovskaya, Aleksandra Seitkalieva, Vladimir Gorbach, Lubov Slepchenko, Natalya Kirichuk, Anna Podvolotskaya, Oksana Son, Liudmila Tekutyeva, and Larissa Balabanova. 2023. "Chitinolytic and Fungicidal Potential of the Marine Bacterial Strains Habituating Pacific Ocean Regions" Microorganisms 11, no. 9: 2255. https://doi.org/10.3390/microorganisms11092255
APA StylePentekhina, I., Nedashkovskaya, O., Seitkalieva, A., Gorbach, V., Slepchenko, L., Kirichuk, N., Podvolotskaya, A., Son, O., Tekutyeva, L., & Balabanova, L. (2023). Chitinolytic and Fungicidal Potential of the Marine Bacterial Strains Habituating Pacific Ocean Regions. Microorganisms, 11(9), 2255. https://doi.org/10.3390/microorganisms11092255

